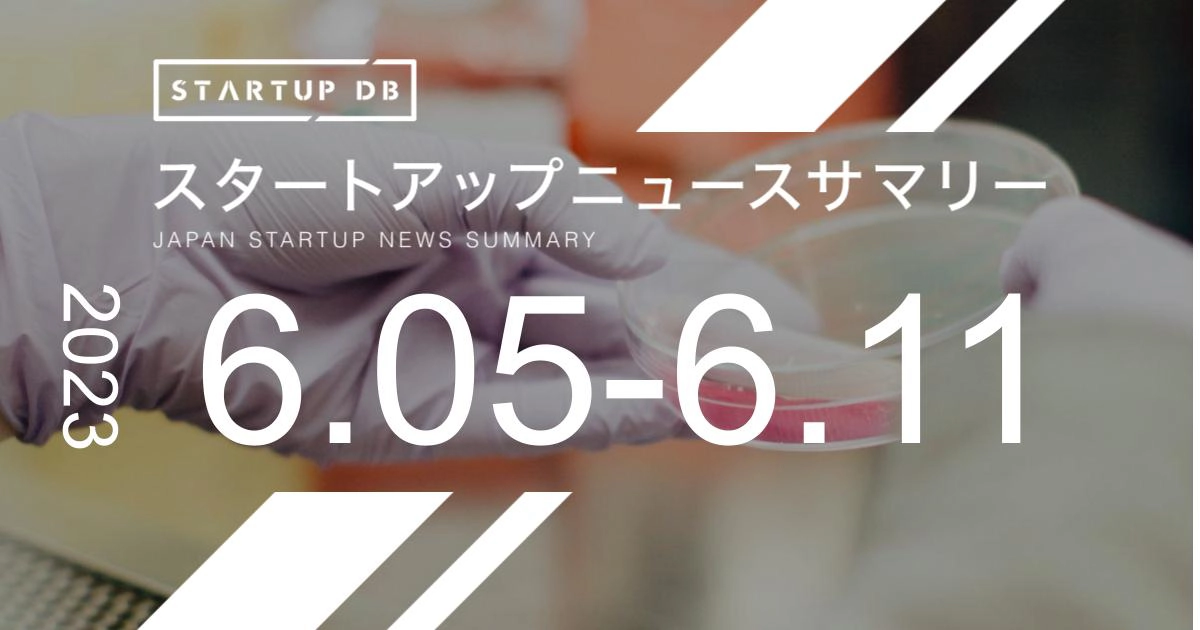

国内の成長産業やスタートアップに関する幅広い情報を収集・整理し、検索可能にした情報プラットフォーム「STARTUP DB」では毎週、スタートアップニュースサマリーを配信している。
「水疱性角膜症」にiPS細胞活用した治療手法を セルージョンが28億3,000万円調達
目の角膜が濁り、最悪の場合失明に至る恐れもある「水疱性角膜症」に対し、iPS細胞を活用した治療法を開発しているセルージョンは6月7日、第三者割当増資で28億3,000万円を調達したと発表した。累計調達額は45億円となった。
同社発表などによると、水疱性角膜症は、目の角膜の一番内側にある「角膜内皮細胞」が減少し、角膜が混濁することで視力障害が起こる。進行性のため、放置すれば失明の恐れもあるという。
セルージョンは独自技術とiPS細胞を組み合わせ、角膜内皮細胞を代替できる「CLS001」を開発する。2023年3月には、共同研究を実施している藤田医科大学と慶應義塾大学の研究チームが初めてCLS001を患者に移植するなど、研究開発も進んでいる。
今回調達した資金で研究開発体制をさらに強化するとともに、グローバルでの治験準備なども進めていく。
匠の技をデジタル化 Fairy Devicesが21億円調達
デジタルデバイスを装着した現場作業員に、熟練工が遠隔地から指導などを行えるソリューションなどを展開するFairy Devices(フェアリーデバイセズ)は6月6日、シリーズBラウンドのセカンドクローズとして21億円を調達したと発表した。
同社は、比較的高齢な熟練工が今後、技術が継承されないまま引退していくことを課題と捉え、属人化されやすい「匠の技」をデバイスやデータ解析などでデジタル化するソリューションを展開している。デバイスを着用した作業員を「コネクテッドワーカー」とし、遠隔地から熟練工が支援する。2019年のサービス発表から3年で、世界18の国と地域で活用されるようになったという。
調達した資金は、プロダクト開発やマーケティング、それに採用などに充てられるという。
グロースステージのスタートアップに融資を UPSIDER Capital設立
法人向けカードを手がけるUPSIDERは6月7日、グロースステージ以降のスタートアップに融資を実行するための子会社・UPSIDER Capitalを設立したと発表した。
同社はこれまでにも法人向けカード事業で、AIを活用した与信評価を元に顧客企業の利用限度額を設定するなどしてきた。こうした実績に加え、同日に発表した業務効率化ツール「AI Coworker」により得られる契約や発注情報などを組み合わせることで「スピーディーかつ大きな金額を融資することが可能」(同社発表)になるとしている。
UPSIDER Capitalからは直接の融資はせず、金融機関に信用情報を提供することで融資を実現するという。
同社は発表のなかで、「世界で戦える日本企業を生み出し、日本の競争力を再び上げることを支援する総合金融機関」を目指すと宣言。「日本の成長を牽引する世界的なユニコーン企業を複数社生み出すことに貢献」するとしている。
注目の資金調達企業
セルージョン
調達額:28億3,000万円調達先:JICベンチャー・グロース・インベストメンツ / ニッセイ・キャピタル / スパークス・アセット・マネジメント / アクシル・キャピタル・パートナーズ2号LLP / Nikon-SBI Innovation Fund / AIS CAPITAL / 東京大学エッジキャピタルパートナーズ / DBJキャピタル / SMBCベンチャーキャピタル / Gemseki投資事業有限責任組合備考:その他投資家含む / AIS CAPITALは運営するファンドを通じて出資
Fairy Devices
調達額:21億円調達先:ダイキン工業 / ヤンマーベンチャーズ / NTTテクノクロス備考:シリーズBラウンドセカンドクローズ / その他投資家含む
レストアビジョン
調達額:12億7,000万円調達先:Remiges Ventures (リード) / ANRI / リアルテックファンド / DBJキャピタル / QBキャピタル / SMBCベンチャーキャピタル / Spiral Capital / 肥銀キャピタル備考:シリーズAラウンド / 優先株式に転換されるJ-KISS型新株予約権2.1億円含む
ピーステックラボ
調達額:10億円調達先:日本郵政キャピタル / JR東日本スタートアップ / イノベーション・エンジン備考:シリーズEラウンドファーストクローズ / JR東日本スタートアップと資本業務提携
AMI
調達額:9億1,000万円調達先:リアルテックホールディングス / 肥銀キャピタル / テレビ熊本 / 日清紡ホールディングス / メディカル・データ・ビジョン / PARAMOUNT BED Healthcare Fund / パラマウントベッド / Kips備考:シリーズBラウンド
注目のスタートアップニュース
UPSIDER Capital
UPSIDER、新プロダクト「AI Coworker」「UPSIDER Capital」のリリースを決定 – 業務効率化ツールおよび成長企業への融資領域に参入https://prtimes.jp/main/html/rd/p/000000060.000076272.html (2023/06/07)
イノベーション投資ファンド
総額100億円のイノベーション投資ファンドを創設https://news.biglobe.ne.jp/economy/0608/prp_230608_8044278260.html (2023/06/08)
JR東日本スタートアップ
JR東日本のCVCが、地域のために、地域に根差した事業の成長支援を行う「JR東日本ローカルスタートアップ合同会社」を設立。https://prtimes.jp/main/html/rd/p/000000209.000034286.html (2023/06/08)
資本業務提携ニュース
ピーステックラボ × JR東日本スタートアップ
ピーステックラボとJR東日本スタートアップは資本業務提携を締結した。今後は駅を拠点としたモノのシェアリングサービスの具現化を推進する方針だ。
https://prtimes.jp/main/html/rd/p/000000062.000042763.html (2023/06/05)
REXEV × 鈴与商事
REXEVと鈴与商事は資本業務提携を締結した。今後は静岡県を始めとした東海地域を中心に、脱炭素ソリューションの展開を推進するほか、EVの普及と新たなソリューション開発に共同で取り組んでいく方針だ。
https://prtimes.jp/main/html/rd/p/000000078.000048307.html (2023/06/05)
DATAFLUCT × 全日本食品
DATAFLUCTと全日本食品は資本業務提携を締結した。今後はデータサイエンスの知見と、全日本食品の食品流通の知見を組み合わせ、物流業界の2024年問題の解決をはじめ、食品流通業界における新たな価値の創出を目指す方針だ。
https://prtimes.jp/main/html/rd/p/000000170.000046062.html (2023/06/07)
HIROTSUバイオサイエンス × 富田薬品
HIROTSUバイオサイエンスと富田薬品は資本業務提携を締結した。九州全域で医薬品の卸売を行う富田薬品のネットワークを活かし、「N-NOSE(エヌノーズ)」を導入する医療施設の開拓を推進する方針。
https://prtimes.jp/main/html/rd/p/000000053.000090131.html (2023/06/08)
TRiCERA × 大日本印刷
TRiCERAと大日本印刷は資本業務提携を締結した。日本をはじめ、アジア諸国を中心とした海外市場における、現代アートの新たなビジネスモデルの創出を目指していく。
https://prtimes.jp/main/html/rd/p/000000389.000069194.html (2023/06/09)
H.I.F × エアトリ
H.I.Fとエアトリは資本業務提携を締結した。H.I.Fとエアトリ双方が保有する機能やノウハウを活用し、持続可能な社会づくりに貢献していく方針。
https://prtimes.jp/main/html/rd/p/000000389.000069194.html (2023/06/09)
M&Aニュース
M&A BASE
M&A発表日:2023/06/08取得日:非公開買収額:非公開買収先:エキサイトホールディングス
STARTUP DB先週のリリース記事
「GPT」の疑問、全部専門家に聞きました。チャットGPT大流行の理由、ビジネスで活用すべきか、国産AIの勝ち筋は… Spiral.AI 佐々木CEO

調達支援サポートのご案内
事業会社やCVCの出資ニーズをもとに、スタートアップ企業に最適な資本業務提携候補をご紹介します。国内外200社以上の事業会社やCVCと情報連携をすることで、出資注力領域や出資可能金額、出資検討期間などの出資ニーズを集約しているこのサービス。スタートアップの資金調達目的やスケジュールに沿った調達可能性がある企業との商談を実現します。